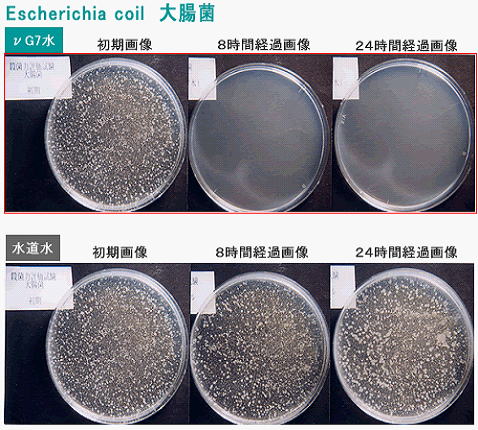
大腸菌とVG7量子水
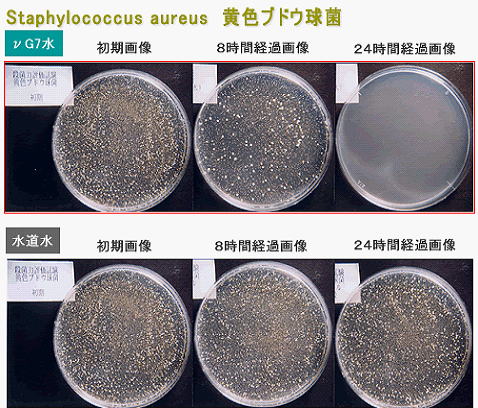
黄色ブドウ球菌とVG7量子水
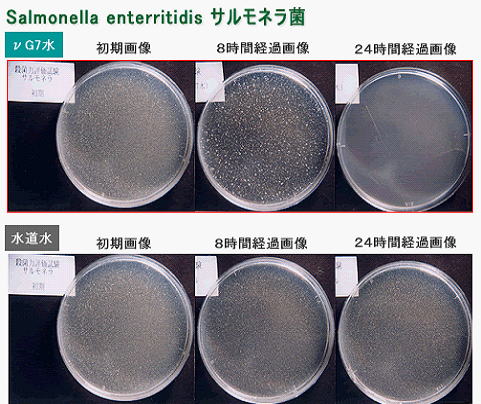
サルモネラ菌とVG7量子水

VG7抗菌力評価試験画像 社団法人 京都微生物研究所
私たちの生活環境には、様々な細菌が棲息しています。
人体も腸内細菌をはじめ常在菌が共存しています。自然界では良い菌・悪い菌といった区別はありません。必要なところに必要な菌が存在しています。
現代は、そのバランスを人間が破壊したために、いろいろの問題が生じています。マスコミでも頻繁にその報道がなされ、薬品会社は次々と抗菌剤・殺菌剤を売り出しています。そして無菌化が当然のように店頭では売れています。
これで本当にいいのでしょうか?
大腸菌
黄色ブドウ球菌
レジオネラ菌

平成15年撮影の写真で、やや不鮮明です。
レジオネラ菌は1時間後に約37%、3時間後に約75%の減少でしたが、24時間後には100%の減少で<検出せず>の結果でした。
温泉施設や浴場で問題になっている菌ですが、免疫力の低下した方が感染すると肺炎を起こし、重篤な場合は死亡を招く場合もあります。このため地方の第3セクターで経営される温泉施設が廃業に追い込まれたケースもあり、厚生労働省はレジオネラ菌の発生防止策を各施設に義務づけています。
サルモネラ菌
サルモネラ菌は、1時間後に約72%、3時間後に約99%の減少、24時間後には100%の減少で<検出せず>の結果でした。
この抗菌作用が、養鶏場ではサルモネラ菌対策が充実することつながり、供給される養鶏場の卵・養豚場などの畜産業(抗生物質などの薬剤が激減でき、経済的にも生産性が向上)のサルモネラ菌食中毒が激減することになります。
24時間抗菌検査試験
平成18年3月、観察時間を24時間に設定し、再度の抗菌検査を(社)京都微生物研究所に依頼しました。 その結果、以前と同様の菌類で100%の抗菌結果を得ることが出来ました。

検査結果の記号が「<10」ですから、「検出せず」の検査結果で、予想を上回る完璧な抗菌数値でした。
畜産農家や青果物の処理加工を営まれるかたより、腐敗臭が激減したり、鮮度の保持期間が延びたり・・・、などの好結果を得られる事実からもニュージーセブンの水が強力に働いていることが理解できます。

